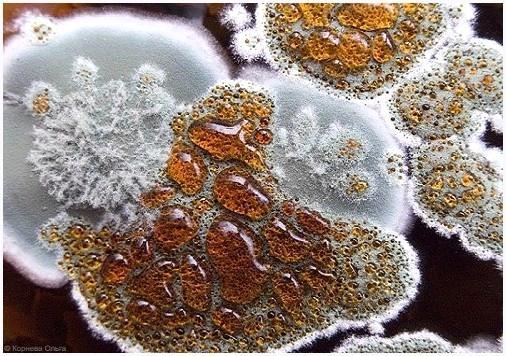

Обработка стен от плесени

Не обращая внимания на то, что один из переходных этапов в развитии медицины связан с открытием плесени, она так и не стала «народной любимицей».
Вероятнее, это связано с повсеместным распространением вездесущего грибка и его свойством, не только портить строительные и отделочные материалы, но и оказывать болезнетворное действие на организм человека, а особенно людей со сниженным иммунитетом, что может стать обстоятельством важных последствий. Как мы знаем, излишняя влажность в помещении может стать обстоятельством появления плесени и грибка, каковые не только портят внешний вид стен, но и вредят здоровью.
Обычно люди страдают от необъяснимой аллергии, астмы и множества других болезней желудочно-кишечного тракта и дыхательной системы. Умелые эксперты, при обнаружении у вас таких болезней, рекомендуют, первым делом, обратить внимание на состояние стен у вас в квартире либо доме и при обнаружении плесени без промедлений начать мероприятия по борьбе с ней. Действенная борьба с плесенью не представляется вероятной без теоретических знаний о ней и условиях ее благоприятного развития. С биологической точки зрения, плесень представляет собой микроскопический грибок, который сам по себе не воображает опасности для человека. Громаднейший вред для человека он несет в момент размножения, в то время, когда его споры начинают выделять токсин, вызывающий аллергические реакции. Многие неопытные мастера, в первый раз столкнувшись с плесенью в квартире, задаются вопросом: «Как удалить грибок со стенку быстро и наиболее действенно?», и данный вопрос очень актуален, поскольку, согласно точки зрения экспертов, единственно надёжный способ сохранить помещение от негативного действия плесени, есть ее удаление. В настоящей статье мы докажем вам это.
Плесень: а вы понимаете врага в лицо?
Вы в первый раз замечаете изменение цвета поверхностей, к примеру, позеленение либо посинение? Нашли тёмные хлопья под потолком либо шелушение стен? Столкнулись с возникновением корочек либо рыхлого порошкообразного налета на продуктах? Знакомьтесь, ваш враг – плесень.
Грибок либо плесень – это применяемое в быту наименование плесневых грибов, отличительной изюминкой которых есть развитый мицелий (грибница), проникающий вглубь питательной среды, именуемой субстратом. Также, плесневые грибы имеют еле заметные плодовые тела, располагающиеся на поверхности субстрата. Их мы в большинстве случаев видим и именуем плесенью. Они не могут к воспроизводству питательных веществ и лишь поглощают готовые, выделяя в вохдух углекислый газ, эфирные масла и токсические продукты своей жизнедеятельности. Потом рассмотрим основные разновидности плесневых грибков.

Разновидности плесневых грибков: краткая черта
Все существующие плесневые грибки, с которыми может столкнуться начинающий либо умелый мастер в сфере строительства, возможно поделить на три подвида:
Плесневые грибки либо классическая плесень – наиболее распространенный подвид плесневых грибов, с которым возможно столкнуться в быту. Они растут на бетоне, камнях, обоях а также лакокрасочных материалах. В начальный период своего развития они являются зеленые, голубые, бурые либо тёмные точки, каковые потом разрастаются, образуя пятна значительных размеров. При долгом действии плесневых грибков на стройматериал, они смогут стать обстоятельством его разрушения фактически на всю глубину;

Грибок синевы, который в ходе своего роста и жизнедеятельности поражает клетчатку древесины. Отличить его от других разновидностей возможно по неприглядным серо-синим пятнам, образующимся на поверхности древесины. Синева, попадая через пленку лакокрасочных материалов, образует в древесине необычные ходы либо водопроводы, по которым вода попадает вовнутрь древесины, и тем самым увеличивается ее влажность. А повышенная влажность, как мы знаем, благоприятное условие для развития плесени. Наиболее довольно часто в таковой замкнутый круг грибкового поражения попадает сосна;

Грибки гниения поражают лишь древесину. Различают белую, бурую и бактериальную гниль. Бактериальная гниль разъедает изнутри древесину, что содействует внутреннему разложению целлюлозы. Наряду с этим материал теряет свои прочностные характеристики, темнеет либо сереет. При поражении древесины белой гнилью она фактически не меняет свой цвет, поскольку гниль разрушает не только древесину, но и лигнин, входящий в ее состав. Еще одна разновидность грибков гниения – бурая гниль, возможно как сухой, так и мокрой. При поражении последней, на древесине неспешно начинают появляться полосы и пятна желтого, коричневого и черного цветов, на месте которых потом появляются трещины. При поражении древесины сухой гнилью пораженные участки покупают коричневый цвет, сжимаются, по окончании чего происходит их раскалывание вдоль и поперек волокон;

Наиболее страшным врагом для человека и его жилища есть белый домовой гриб. Дабы вы смогли оценить масштабы его опасности, напомним, что за месяц, боровик может всецело поразить пол из дубовых досок толщиной 40 мм. Исходя из этого в древности, дабы не допустить распространение грибка, дома, пораженные древесиной, сжигали;

Кроме вышеописанных грибковых микроорганизмов, существуют еще одна разновидность микроорганизмов, рука об руку идущих с классическим грибком. Речь заходит о высолах, поражающих цементные, кирпичные, оштукатуренные либо облицованные мрамором фасады. Они являются щелочной либо соляной налет, образующийся на указанных поверхностях в сухую погоду, в составе которых обнаруживаются нерастворимые соли серной кислоты, карбонаты либо силикаты.

Основные обстоятельства появления грибка и плесени на стенах
Основополагающая обстоятельство появления плесени – излишняя влага, которая образуется не только в помещениях, но и в строительных перегородках, что обусловлено ошибками, допущенными в ходе укладки изоляции горизонтальных и вертикальных фундаментов. Помимо этого, обстоятельством влажности смогут быть неисправности в системах вентиляции. Парадокс содержится в том, что производители позиционируют пластиковые окна как систему высокой плотности, но они смогут лишь усугубить неприятности, связанные с неэффективной вентиляцией и микроклиматом помещения. Вторая обстоятельство происхождения грибка – промерзание стен.
Плесень и грибок смогут распространяться на поверхности не только деревянных, но и кирпичных стен, наряду с этим во втором случае масштабы неприятности не так безграничны, поскольку чтобы от нее избавиться, достаточно грибок с поверхности стенки. В случае поражения древесины единственно верным средством от плесени на стенах есть удаление пораженного участка древесины и его сжигание. В связи с тем, что темпы размножения грибка высокие, и за год он может поразить древесину на 70 %, он страшен не только для поверхностей и конструктивных элементов здания, но и для мебели.

Принципиально важно! Дабы провести действенную борьбу с грибком и верно ответить на вопрос: «Как избавиться от плесени на стенах?», нужно знать обстоятельство ее появления, что разрешит подобрать комплекс действенных мероприятий по борьбе с ней и верить в их надежности и долговечности.
Основные факторы, содействующие формированию грибка:
Промерзание наружных стен – в случае если по краям и в углах стен вы нашли чёрный налет, вы имеете возможность быть уверены, что обстоятельство его появления – промерзание стен. Чтобы устранить плесень на стенах, нужно их просушить и проверить сцепление штукатурки;
Влага, идущая из грунта, в присутствии которой возможно удостовериться, найдя потеки в местах соединения пола первого этажа либо подвала и стен. В этом случае нужно удостовериться в эффективности горизонтальной изоляции фундаментных стен. В случае ее повреждения нужно осуществить ее ремонт, предварительно просушив стенки. В случае если пол кроме этого оказался мокрым, вероятнее ремонт изоляции не удастся произвести, не удалив фундамент;
Неисправность водопроводной канализации, о которой может свидетельствовать появление жидкости вдоль водопроводных труб. Еще одним знаком неисправности водопроводной канализации смогут быть мокрые следы на стене на высоте края ванны рядом от ванной комнаты. В большинстве случаев, осушение оказывает помощь решить проблему, но в случае запоздалого обнаружения указанных сигналов может привести к чрезмерному распространению грибка и неосуществимости его стремительного уничтожения;

Протекающий водосток и желоба, в большинстве случаев, возможно найти лишь снаружи, в случае появления потеков на штукатурке. В дождливую погоду, в то время, когда влага превышает предельно допустимые нормы, потеки смогут появляться и в центре. Обычно неопытные мастера не придают данной проблеме особенного значения, считая ее само собой разумеющейся,, пока она не достигнет определенных масштабов. Но, утечки, покинутые без присмотра, смогут создать настоящую проблему лишь зимний период, в то время, когда случится промерзание воды в штукатурке;
Неисправность вентиляционных систем ванной комнаты либо кухни – еще одна обстоятельство происхождения плесени на стенах, поскольку указанные помещения характеризуются относительно высокой влажностью воздуха, что содействует быструю формированию грибка. Что касается мест, наиболее подверженных появлению грибка, то к ним относятся не хорошо вентилируемые места, в частности, углы стен. В громаднейшей степени это относится и новостроек, в которых стенки еще достаточно плотные. В этом случае особенное внимание нужно выделить проветриванию комнат либо установить систему кондиционирования.

Перед тем как ответить на вопрос: «Как убрать плесень на стенах?», подведем итог сказанному выше и выделим основные обстоятельства образования грибка:
- Применение стройматериалов, характеризующихся большим уровнем остаточной влажности;
- Неэффективная гидроизоляция межпанельных швов;
- Некачественная гидроизоляция фундаментов;
- Чрезмерно высокая герметичность помещений, в которых установлены пластиковые окна и не хватает действенная естественная вентиляция помещений;
- Нарушенный отопительный баланс квартиры, проявляющийся в виде неравномерного прогрева помещений при высокой влажности снаружи;
- Происхождение недостатков кровли и намокание стен при косых дождях;
- Переизбыток комнатных растений, нередкие стирки, сочетающиеся с недостаточным проветриванием.

Профилактические мероприятия и устранение обстоятельств появления грибка
Прежде, чем приступить к обработке стен от плесени, нужно разобраться в обстоятельствах ее происхождения, каковые мы рассмотрели выше. В связи с тем, что грибок появляется во мокрых помещениях с недостаточной вентиляцией, профилактические мероприятия направлены на выравнивание температуры и влажности, для чего по окончании тщательного просушивания нужно отказаться от плотного закрывания дверей. При недостаточной вентиляции помещения в вентиляционном канале устанавливают вентилятор.

Обработка стен от грибка и плесени: пошаговое управление
Как правило грибок поражает слой штукатурки, который потом подлежит обработке. Но перед тем, как приступить к обработке стен от грибка и плесени, нужно проверить сцепление штукатурного слоя с поверхностью стенки. Для этого по всей поверхности стенки нужно постучать молотком. В случае появления глухого звука, вы имеете возможность быть уверенны, что штукатурка испортилась и отделилась от стенки. Из этого делаем вывод, что она подлежит удалению с последующей заменой. В случае если сцепление штукатурки с поверхностью стенки есть надежным, поверхность стенки нужно обработать специализированным антисептиком для стен от плесени. Наряду с этим нужно четко следовать инструкции, предлагаемой производителем антисептического препарата.

Перед началом работы, поверхность обрабатываемой стенки нужно шепетильно намочить водой, дабы не допустить распространение спор грибка в помещения. Применяя железную щетку либо шпатель, очистите пораженное место от плесени и других видов грибка, всецело удалив наряду с этим рыхлый слой штукатурки. Дабы повысить эффективность данного мероприятия, обработайте цементные стенки особым очищающим раствором, содействующим открытию пор цементного раствора.

Принципиально важно! В ходе удаления грибка нужно применять особые средства защиты — маски, респираторы и перчатки, и обеспечить действенную вентиляцию помещения, поскольку вдыхание частичек плесени и спор грибка угрожает страшными последствиями для здоровья. Помимо этого, обеспечив нужные условия, вы предотвратите распространение грибка на непораженных участках. Если вы планируете эксплуатировать помещение сразу после обработки, вы должны знать, что она обязана осуществляться по окончании 48 часов по окончании завершения работ.

Осуществив удаление пораженных участков, нужно сжечь инфицированные фрагменты штукатурки.
Потом нужно произвести обработку очищенной поверхности особым антисептическим раствором. По окончании предварительного разведения раствора водой нанесите раствор на пораженный участок стенки с запасом в 1 метр с каждой стороны, дабы точно не допустить зарождающиеся колонии. Для нанесения антисептического состава применяйте валик, кисть либо пистолет-распылитель.
Принципиально важно! Производители предлагают обратить внимание на фунгициды (противогрибковые препараты), продающиеся в виде спреев в особых баллончиках-распылителях. В связи с тем, что в этом случае количество спрея будет маленьким (около 0,5 литров), данное решение подойдет для помещений с маленькой площадью. Данный состав наносят в два либо три слоя, наряду с этим любой последующий слой наносится по окончании подсыхания прошлого.

Потом реализовывают грунтовку стен грунтовочным составом глубокого проникновения, владеющим антисептическими либо фунгицидными свойствами. По окончании того, как поверхность всецело высохнет, нужно повторно нанести грунтовочный состав. В заключение создают шпаклевку, штукатурку и финишную отделку стен.
Если вы столкнулись с очень сильно запущенным случаем, и грибок развился так, что успел проникнуть в глубокие слои отделочных материалов (особенно пористых) с формированием в них грибницы, ее нужно всецело удалять, из чего возможно сделать вывод, что наружная обработка не принесет должных результатов, а лишь на время скроет внешние следы поражения. В этом случае, если вы имеете возможность всецело заменить пораженный фрагмент отделочных материалов, не пренебрегайте этим и последуйте совету экспертов.

Чем обработать стенки от плесени? Выбор действенного антисептика
Рынок предлагает много препаратов, действенно борющихся с плесенью и грибком на стенах, и дабы сделать верный выбор, нужно шепетильно изучить сопроводительную инструкцию к препарату и проконсультироваться с продавцом. Это обусловлено тем, что препараты, действенно ликвидирующие один вид грибка, смогут быть не действенны в борьбе с другой разновидностью данного микроорганизма. Но, существуют и универсальные препараты, каковые смогут употребляться как в помещения, так и для обработки фасадов зданий. На рынке вы имеете возможность заметить составы, продающиеся в готовом виде, и сухие смеси, нуждающиеся в разведении. В качестве растворителя смогут употребляться уайт-спирит, вода либо скипидар. Рассмотрим наиболее распространенные антисептические и фунгицидные составы:
- Atlas Mykos – средство, предназначенное для борьбе не только с плесенью, но и лишайниками, мхом либо водорослями. Оно продается в виде концентрата и может употребляться в произвольных помещениях с повышенной влажностью, и для обработки фасадов зданий. Перед применением его разводят водой в соотношении 1:2, а в случае обработки минеральных поверхностей данное соотношение образовывает 1:5;
- Spectrum Фунгицид – средство, действенно уничтожающее грибок на деревянных, оштукатуренных и обработанных лакокрасочными материалами поверхностях. Может употребляться как снаружи, так и в помещений, подверженных повышенной влажности;
- Ксиолат – действенное средство, разрушающее структуру плесени и на молекулярном уровне поникающее в межмолекулярную структуру любого стройматериала, к примеру, дерева, кирпича, бетона и других;
- Тефлекс – замечательный препарат, удаляющий плесень и грибок, характеризующийся экологической безопасностью и долговечностью, в связи с чем, есть надёжным для человека и животных;
- FILASMUFFY – средство, продающееся в виде спрея и действенно удаляющее плесень с поверхности обоев, штукатурки, бетона либо кирпича;
- Снежка Пропитка – есть действенным противогрибковым средством, удаляющим не только плесень и грибок, но и водоросли, лишайники и мхи с поверхности кирпичной кладки, штукатурки и лакокрасочных покрытий. Употребляется как снаружи, так и в помещения.

Народные средства, действенные при борьбе с плесенью
С покон веков для борьбы с плесневыми грибками употреблялись и народные средства, эффективность которых иногда может превосходить новомодные препараты. Рассмотрим наиболее узнаваемые и действенные народные средства:
1.Своими фунгицидными свойствами с покон веков славится креозот, употребляющийся для обработки поверхностей, пораженных грибком и плесенью;
2. Помимо этого, для действенной борьбы с плесенью употребляются следующие растворы, каковые в 10 литрах воды содержат следующие компоненты:
- 2 литра уксусной эссенции и 500 г бронзового купороса против плесени;
- 1,5 кг фторида натрия, 500 г бронзового купороса и столько же металлического купороса;
- 900 г бура, 400 г борной кислоты и 1, 4 л 6 % уксуса.
Перед применением растворы указанных составов нужно нагреть до 60-70 градусов, по окончании чего, применяя валик либо кисть, нанести на пораженный участок и покинуть до окончательного просыхания. Обработку нужно повторить через месяц.

3.Для обработки кирпичных стен кроме этого существуют народные способы, подразумевающие применение:
- Промышленной 70 %-ной перекиси водорода;
- Соды, разведенной до кашицеобразного состояния;
- Смеси пищевого уксуса с водой;
- Смесь медицинского спирта и глицерина в соотношении 1 : 1;
- Щелочи либо хлорки.






